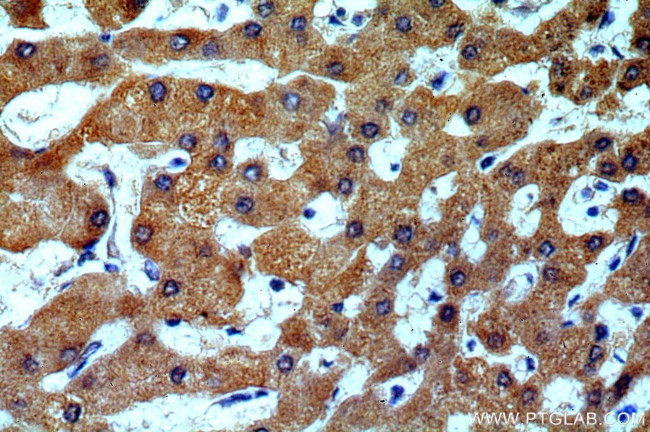
H6PD Antibody in Immunohistochemistry (Paraffin) (IHC (P))
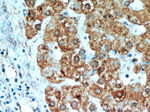
H6PD Antibody in Immunohistochemistry (Paraffin) (IHC (P))

Search
Proteintech
H6PD Polyclonal Antibody
{{$productOrderCtrl.translations['antibody.pdp.commerceCard.promotion.promotions']}}
{{$productOrderCtrl.translations['antibody.pdp.commerceCard.promotion.viewpromo']}}
{{$productOrderCtrl.translations['antibody.pdp.commerceCard.promotion.promocode']}}: {{promo.promoCode}} {{promo.promoTitle}} {{promo.promoDescription}}. {{$productOrderCtrl.translations['antibody.pdp.commerceCard.promotion.learnmore']}}
产品信息
15255-1-AP
种属反应
宿主/亚型
分类
类型
抗原
偶联物
形式
浓度
规格
纯化类型
保存液
内含物
保存条件
运输条件
产品详细信息
This antibody is specific to H6PD.
Immunogen sequence: LSDYYAYSP VQERDAHSVL LSHIFHGRKN FFITTENLLA SWNFWTPLLE SLAHKAPRLY PGGAENGRLL DFEFSSGRLF FSQQQPEQLV PGPGPAPMPS DFQVLRAKYR ESPLVSAWSE ELISKLANDI EATAVRAVRR FGQFHLALSG GSSPVALFQQ LATAHYGFPW AHTHLWLVDE RCVPLSDPES NFQGLQAHLL QHVRIPYYNI HPMPVHLQQR LCAEEDQGAQ IYAREISALV ANSSFDLVLL GMGADGHTAS LFPQSPTGLD GEQLVVLTTS PSQPHRRMSL SLPLINRAKK VAVLVMGRMK REITTLVSRV GHEPKKWPIS GVLPHSGQLV WYMDYDAFLG (443-791 aa encoded by BC081559)
靶标信息
The cystatin superfamily encompasses proteins that contain multiple cystatin-like sequences. Some of the members are active cysteine protease inhibitors, while others have lost or perhaps never acquired this inhibitory activity. There are three inhibitory families in the superfamily, including the type 1 cystatins (stefins), type 2 cystatins and the kininogens. The type 2 cystatin proteins are a class of cysteine proteinase inhibitors found in a variety of human fluids and secretions. The cystatin locus on chromosome 20 contains the majority of the type 2 cystatin genes and pseudogenes. This gene is located in the cystatin locus and encodes a type 2 salivary cysteine peptidase inhibitor. The protein is an S-type cystatin, based on its high level of expression in saliva, tears and seminal plasma. The specific role in these fluids is unclear but antibacterial and antiviral activity is present, consistent with a protective function.
仅用于科研。不用于诊断过程。未经明确授权不得转售。
生物信息学
蛋白别名: 6-phosphogluconolactonase; G6PD, H form; GDH/6PGL endoplasmic bifunctional protein; glucose 1- dehydrogenase; glucose 1-dehydrogenase; glucose dehydrogenase; glucose dehyrogenase; glucose-6-phosphate dehydrogenase 1; glucose-6-phosphate dehydrogenase, salivary
基因别名: AI785303; CORTRD1; G6pd1; G6PDH; GDH; Gpd-1; Gpd1; H6PD; H6PDH
UniProt ID: (Human) O95479, (Mouse) Q8CFX1
Entrez Gene ID: (Human) 9563, (Mouse) 100198, (Rat) 298655